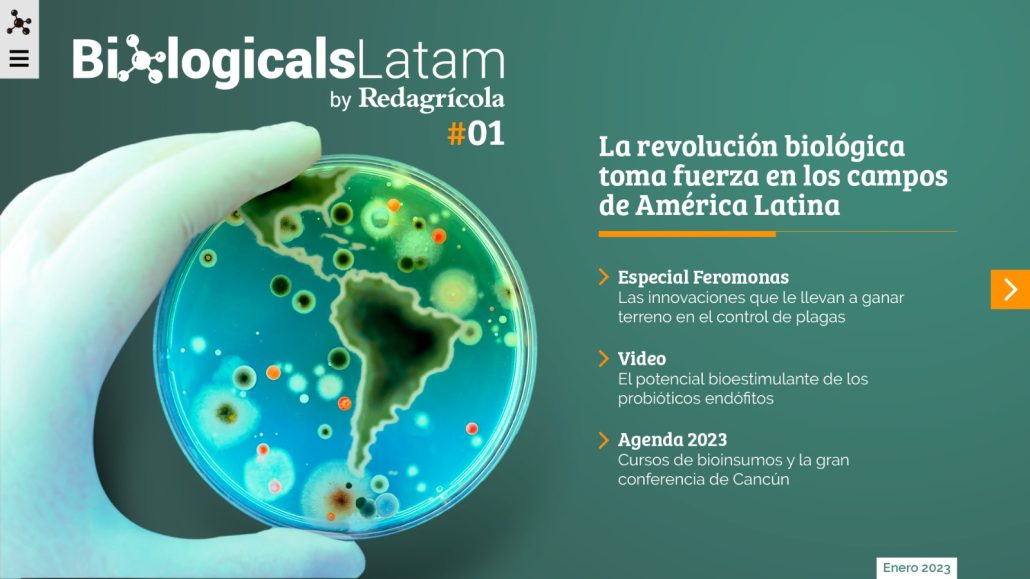

Una eminencia en el estudio del microbioma de la rizósfera presente en el 4° Congreso Bioestimulantes Latam
El doctor Rodrigo Mendes, investigador senior de Embrapa de Brasil, abordará cómo el futuro de la agricultura sustentable se basa en el microbioma de la rizósfera.